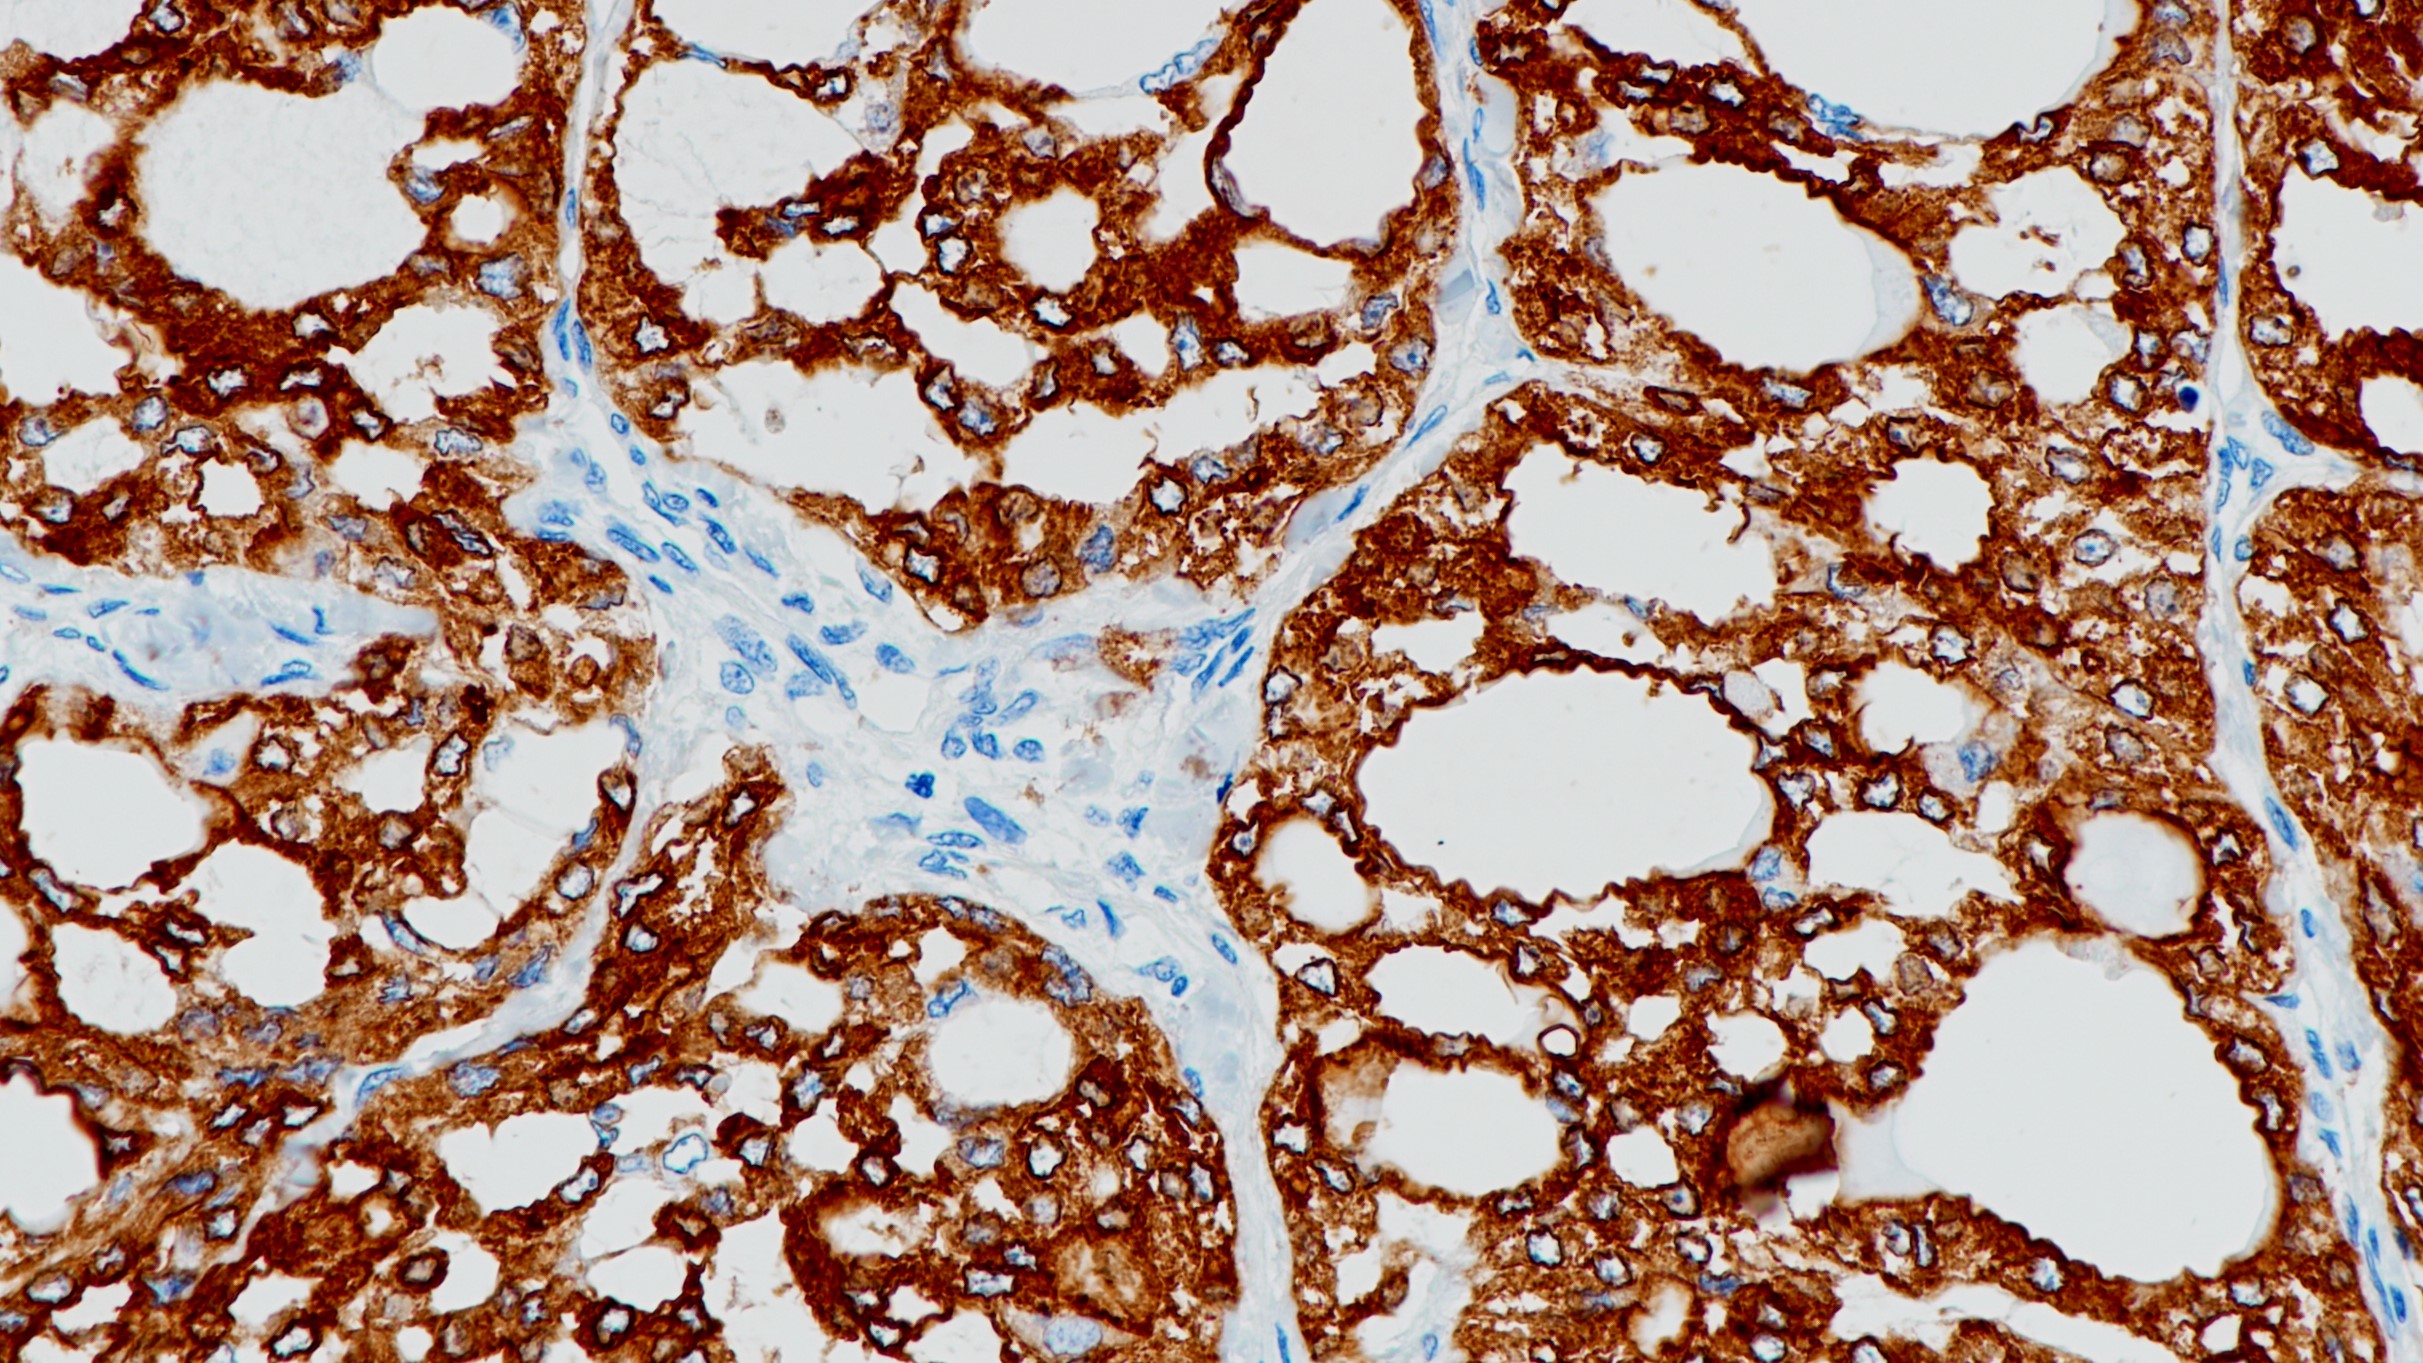
甲状腺癌TPO(BP6071)染色

1. Rebuffat S A , Morin M , Nguyen B , et al. Human recombinant anti-thyroperoxidase autoantibodies: in vitro cytotoxic activity on papillary thyroid cancer expressing TPO[J]. British Journal of Cancer, 2010, 102(5):852-861.
2. Micco C D, Zoro P, Garcia S, et al. Thyroid peroxidase immune-detection as a tool to assist diagnosis of thyroid nodules on fine-needle aspiration biopsy[J]. European Journal of Endocrinology, 1994, 131(5):474.
3.中华医学会.《临床技术操作规范·病理学分册》.人民军医出版社,2004.